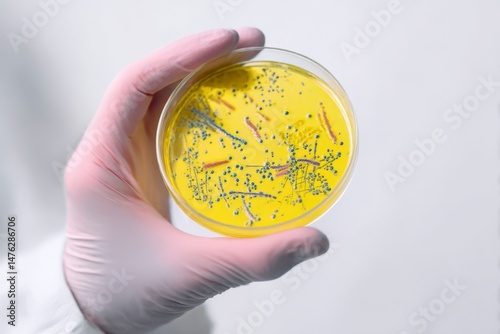

Scientist holding Petri dish with microbes on white background
Dobierz idealny dla Ciebie rozmiar i zamów ten obraz na Twoją ściane. Na drukowanych obrazach nie występuje znak wodny "Adobe Stock" oraz numer wzoru.
Rozmiar wydruku
Szerokość: {{ imgW }}cm
Wysokość: {{ imgH }}cm
Szerokość
Wysokość
Specyfikacja wydruku
Materiał
Grubość ramy
Sposób zadrukowania boków
Chcesz dodać dedykacje?
Suma: {{ price }} zł
{{ netPrice }}zł netto
Cena brutto bez rabatu {{ clientRabat }}%: {{ priceWoRabat }}zł
Twoje przesłane zdjęcia:
Plik jest zbyt niskiej rozdzielczości, żeby wykorzystać go do wydruku, prześlij inne zdjęcie (minimum {{ tooSmallImageWarning }}) lub kliknij i dowiedz się więcej.
Produkt dodany do koszyka
{{ imgW }}x{{ imgH }} cm

Obraz drukowany na płótnie - Scientist holding Petri dish with microbes on white background
Cena za obraz 95x60 cm - 201 zł
specyfikacja: Scientist holding Petri dish with microbes on white background
-
Typ produktuObraz drukowany na płótnie
-
NazwaScientist holding Petri dish with microbes on white background
-
Płótno:Canvas 380g
-
DrukAtramentowy
-
DrukarkaEpson SC S80610
-
AtramentyEpson Ultrachrome GS3
-
Dostępnośćna stanie
-
CenaObraz 95x60 cm - 201 zł
-
ZastosowanieDekoracje domowe, przestrzenie komercyjne, biura, hotele
-
WykończenieNaciągnięcie na ramę, gotowy do zawieszenia
-
Gwarancja24 miesiące
-
ProducentGaleriaDruku
-
Opis
Wideo Prezentacja produktów
Tak może prezentować się Twój obraz.
Sprawdź wizualizacje dla obrazu Scientist holding Petri dish with microbes on white background drukowanym na płótnie. Przedstawiamy kilka wizualizacji wydruku w różej aranżacji oraz kolortyce ścian. Wizualizacje uwzględniają wydruk całego pliku, dokładny kadr i rozmiar możesz wybrać podczas konfigurowania obrazu na górze strony.
Na drukowanych obrazach nie występuje znak wodny "Adobe Stock" oraz numer wzoru.

Więcej z tej serii
Jeśli interesuje Cię to zdjęcie, zobacz więcej z tej serii.






